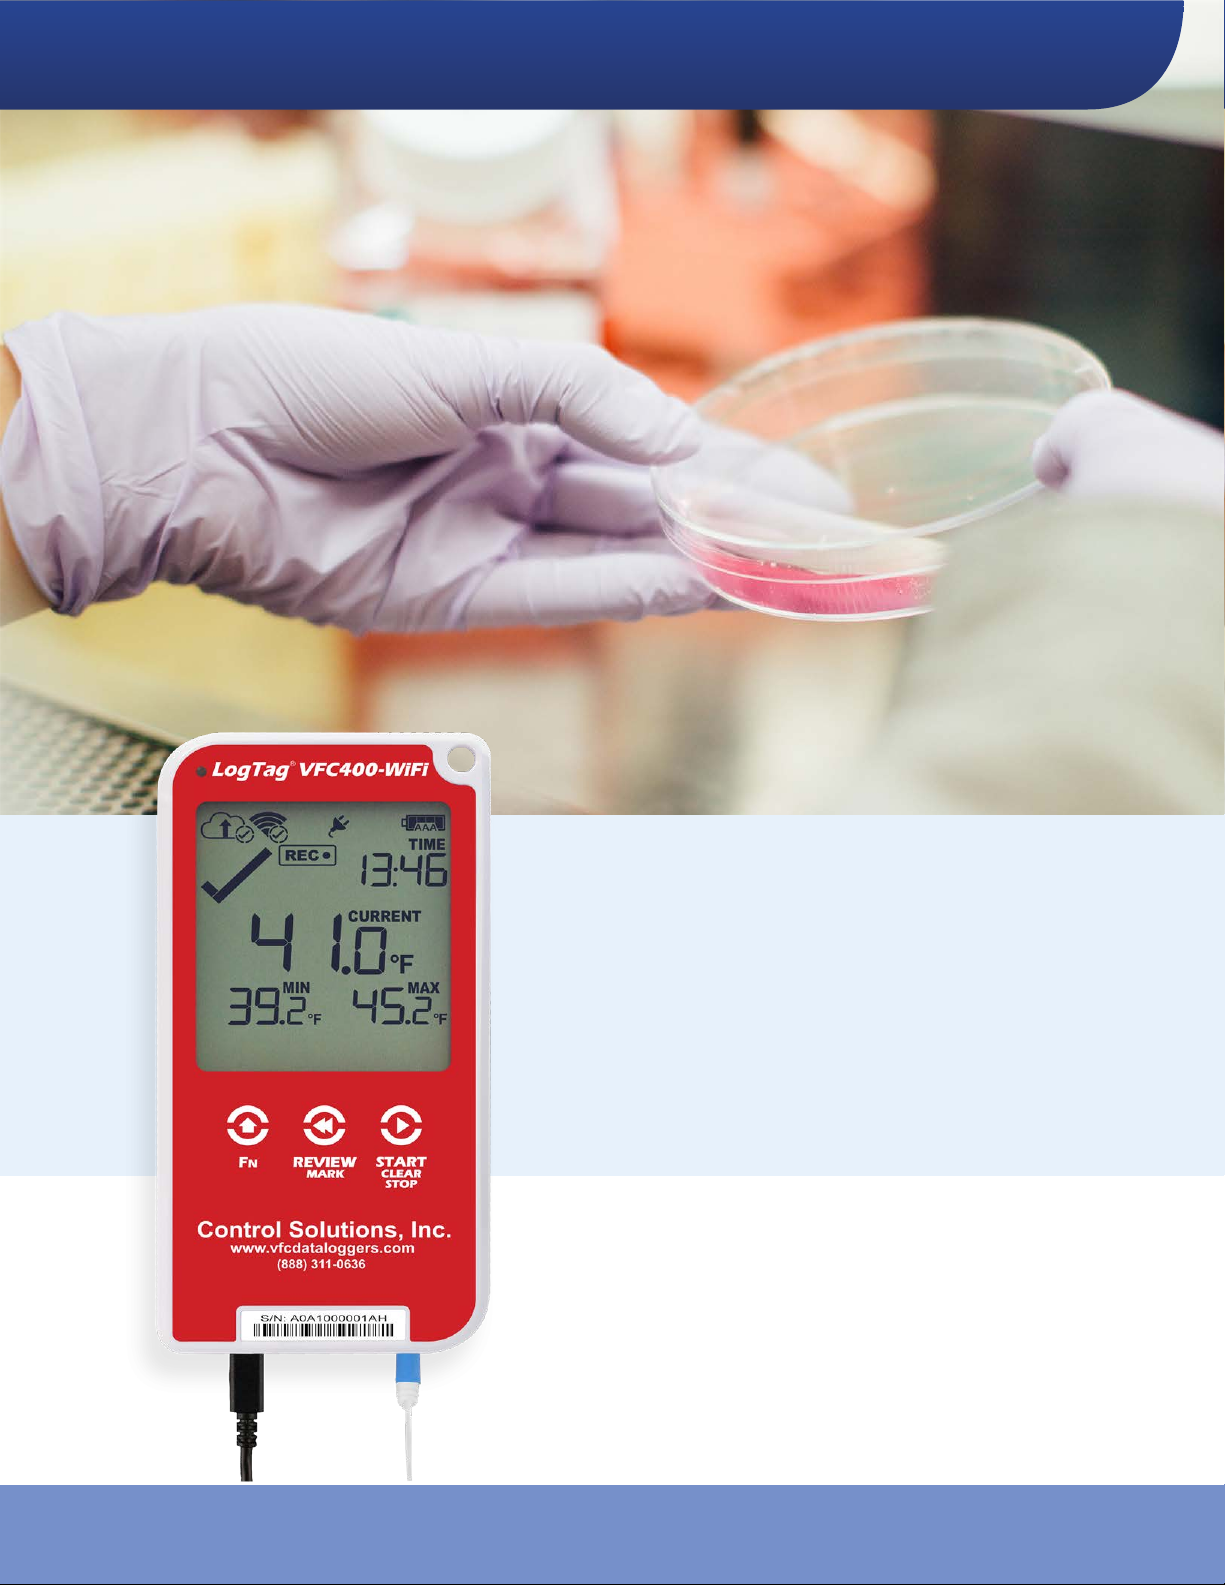

Safety Information VFC400-WiFi User Guide 4
Safety Information
The VFC400-WiFi PDF USB temperature logger contains two "AAA" non-rechargeable backup batteries. These
batteries can be replaced as detailed in Replacing the AAA batteries.
The logger also contains a non-rechargeable secondary backup battery (LiMnO2 CR2032 coin cell).
When this battery indicates “LOW” ( ), it can be replaced by a qualified technician.
Please contact your distributor for further information and also refer to the section
about Powering the VFC400-WiFi on page26.
Keep out of the reach of children!
Do not expose the logger to extreme temperatures as it may lead to the destruction
of the battery and may cause injuries.
Empty batteries should be recycled or disposed of according to your local regulations.
Liability
Control Solutions’s standard warranty terms apply. A copy can be requested by emailing
support@vfcdataloggers.com. In addition, Control Solutions shall not be held liable:
lIf the device was used beyond Control Solutions’s stated limitations
lFor any claims due to the improper storage and use of the device
lFor any problems with refrigeration units
lFor the bad quality of the monitored goods, if any
lFor incorrect readings if the device was used with a low battery
lFor consequential loss
Battery Life
The batteries in the VFC400-WiFi are designed to power the device for up to 3 months in case of a power
failure, provided:
lfresh batteries from a reputable manufacturer are used
ldata are reviewed on the display no more than once daily for 30 seconds
lthe recording interval is not shorter than 5 minutes
la strong wireless signal is available where the VFC400-WiFi is deployed
lthe acoustic alarm is not active over long periods
lthe device is stored and operated according to Control Solutions’ recommendations
Please refer to Powering the VFC400-WiFi on page26 for more information.
Disclaimer
The VFC400-WiFi monitors temperature exposure and not the quality of the goods it accompanies. Its purpose
is to signal if product quality evaluation/testing is required.
Typographical Conventions
Text in this font refers to buttons on the VFC400-WiFi.
Text in this font refers to option settings, dialogue boxes or actions to be taken in Control Solutions VTMC.
Text in this font describes features of the product.
WiFi, cloud connection, airplane, power and low battery symbols may not be shown on all screens.